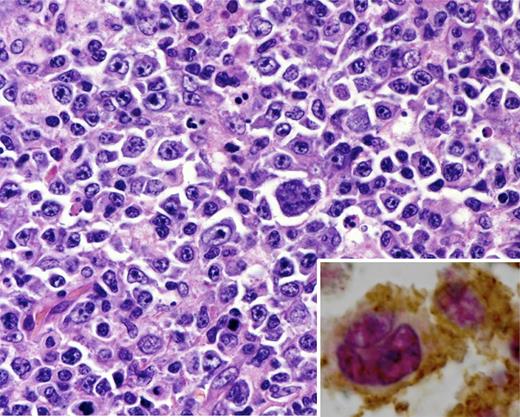
Lymph node biopsy from a patient with EBV+ LBCL. The cells are pleomorphic including the presence of Hodgkin-like cells. Inset, the neoplastic B cells are positive for PAX5 (red nuclear stain) and strongly express PD-L1 (brown), which may inhibit the host antitumor response. Hematoxylin and eosin, original magnification ×250; inset, double immunostain for Pax5 (red) and PD-L1 (brown).

In this issue of Blood, Nicolae et al at the National Cancer Institute describe a series of Epstein-Barr virus–positive (EBV+) diffuse large B-cell lymphomas (DLBCLs) in young patients (median age 23 years) without known immunodeficiency.1
Lymph node biopsy from a patient with EBV+ LBCL. The cells are pleomorphic including the presence of Hodgkin-like cells. Inset, the neoplastic B cells are positive for PAX5 (red nuclear stain) and strongly express PD-L1 (brown), which may inhibit the host antitumor response. Hematoxylin and eosin, original magnification ×250; inset, double immunostain for Pax5 (red) and PD-L1 (brown).
Lymph node biopsy from a patient with EBV+ LBCL. The cells are pleomorphic including the presence of Hodgkin-like cells. Inset, the neoplastic B cells are positive for PAX5 (red nuclear stain) and strongly express PD-L1 (brown), which may inhibit the host antitumor response. Hematoxylin and eosin, original magnification ×250; inset, double immunostain for Pax5 (red) and PD-L1 (brown).
This suggests a paradigm shift from the prevailing dogma that EBV+ DLBCL is limited to the elderly. The original name, senile EBV-associated lymphoproliferative disorder,2 implied a relationship to the weakness of old age. The World Health Organization (WHO) in 2008 adopted a less pejorative term, EBV+ DLBCL of the elderly, which still rankled many patients and their treating physicians because old age was defined as >50 years.3 The current study indicates that in addition to senescence of the immune system in older individuals, a similar spectrum of lymphoma occurs in young immunocompetent patients, possibly related to alterations in the immune environment, which in turn may be modulated by EBV. Cases of EBV+ large B-cell lymphomas (LBCLs) showed high programmed death ligand 1 (PD-L1) positivity in the tumor cells (see figure) and expression of PD-L1 and indoleamine 2,3-dioxygenase in the microenvironment, and it is postulated that these factors contribute to dysregulation of immune checkpoints and tumor immune escape.
Diagnosis of EBV-related DLBCL may be problematic due to the variable histologic appearance and overlap with other EBV-related lymphoid proliferations.4-6 The lymphoma may be nodal or extranodal, and many patients have a high International Prognostic Index with a prognosis that is inferior to that of EBV-negative (EBV−) DLBCL even when adjusted for age. Geographical necrosis is common, and there is a histologic continuum from polymorphous to diffuse proliferation of large cells. Histologic features may overlap with Hodgkin lymphoma, and polymorphous cases are similar to those seen in the posttransplantation setting. In addition to DLBCL-not otherwise specified, cases in young patients described by Nicolae et al had a T-cell/histiocyte-rich LBCL–like or gray zone appearance. The malignant cells are variably positive for EBV-encoded small RNAs (EBERs), EBV latent membrane protein 1 (LMP1), and EBV nuclear antigen 2 (EBNA2), with EBV latency pattern II or III. Those in the younger age group were predominantly latency type II. Latency II (LMP1+, EBNA2−) is a pattern more in keeping with an immunocompetent patient. LMP1 was expressed in most tumor cells. A requirement for the diagnosis is that the malignant cells rather than the background inflammatory cells express EBV. The lymphomas usually have a non–germinal center B or activated B-cell phenotype (CD10−, IRF4/MUM1+). There is clonal rearrangement of immunoglobulin genes, which may help differentiate neoplastic proliferations from reactive hyperplasia and infectious mononucleosis of the elderly.
Cases that histologically resemble EBV+ DLBCL occasionally present in the oropharynx and skin with localized sharply circumscribed mucocutaneous ulcers. They are more common in older female patients, some of whom have been treated with methotrexate for rheumatoid disease.7-9 Histologically, there is surface ulceration and a polymorphous lymphoid proliferation that includes atypical immunoblasts that can resemble Hodgkin cells, and a brisk inflammatory reaction at the base of the ulcer. The lesions tend to remain indolent without progression, but may recur. By contrast, patients with secondary cutaneous involvement by systemic EBV-related lymphoproliferative disorder do poorly.
In contrast with older individuals, the younger patients described by Nicolae et al had predominantly nodal disease and had a favorable outcome. The term “of the elderly” is no longer valid with reference to EBV+ LBCL, and it is likely that it will be eliminated in the update of the WHO classification which is in progress.10 This study provides an argument for screening cases of DLBCL for EBV (EBER, LMP1, and possibly EBNA2) in young as well as elderly or immunosuppressed patients.
Conflict-of-interest disclosure: The author declares no competing financial interests.